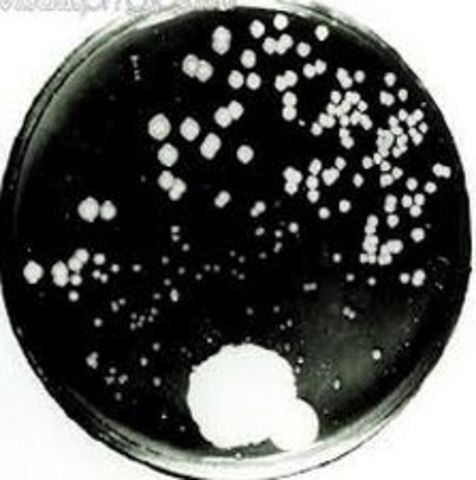
The Discovery

-
In the 1920's Alexander Fleming was searching for an effective antiseptic. He discovered Iysozome. Iysozome is an enzyme which is natuarlly found in sweat and tears.
-
-
Alexander Fleming was tidying his lab because it was very messy and came accross a pile of petri dishes which had bacteria that had been growing and he had forgotten.He decided to take a look at them before putting the petri dishes in to clening fluid.Alexander Fleming saw on a paticular sample that all around the mould the bacteria he had been growing was dead.Then he mad a prediction that a strain called Penicillium notatum must have killed the bacteria therefore he set up a control experiment
-
Alexander Fleming found that he had two petri dishes. One of them had mould on it and the other one did not. The dish with the mould had dead bacteria while the dish without the mould did not and the bacteria continued to grow. Alexander Fleming then concluded that his prediction must be right.
Want to make a timeline like this?
Use Timetoast to turn dates, events, milestones, and phases into a clear visual timeline you can build and share. Timetoast is a timeline maker for work, school, research, and stories.